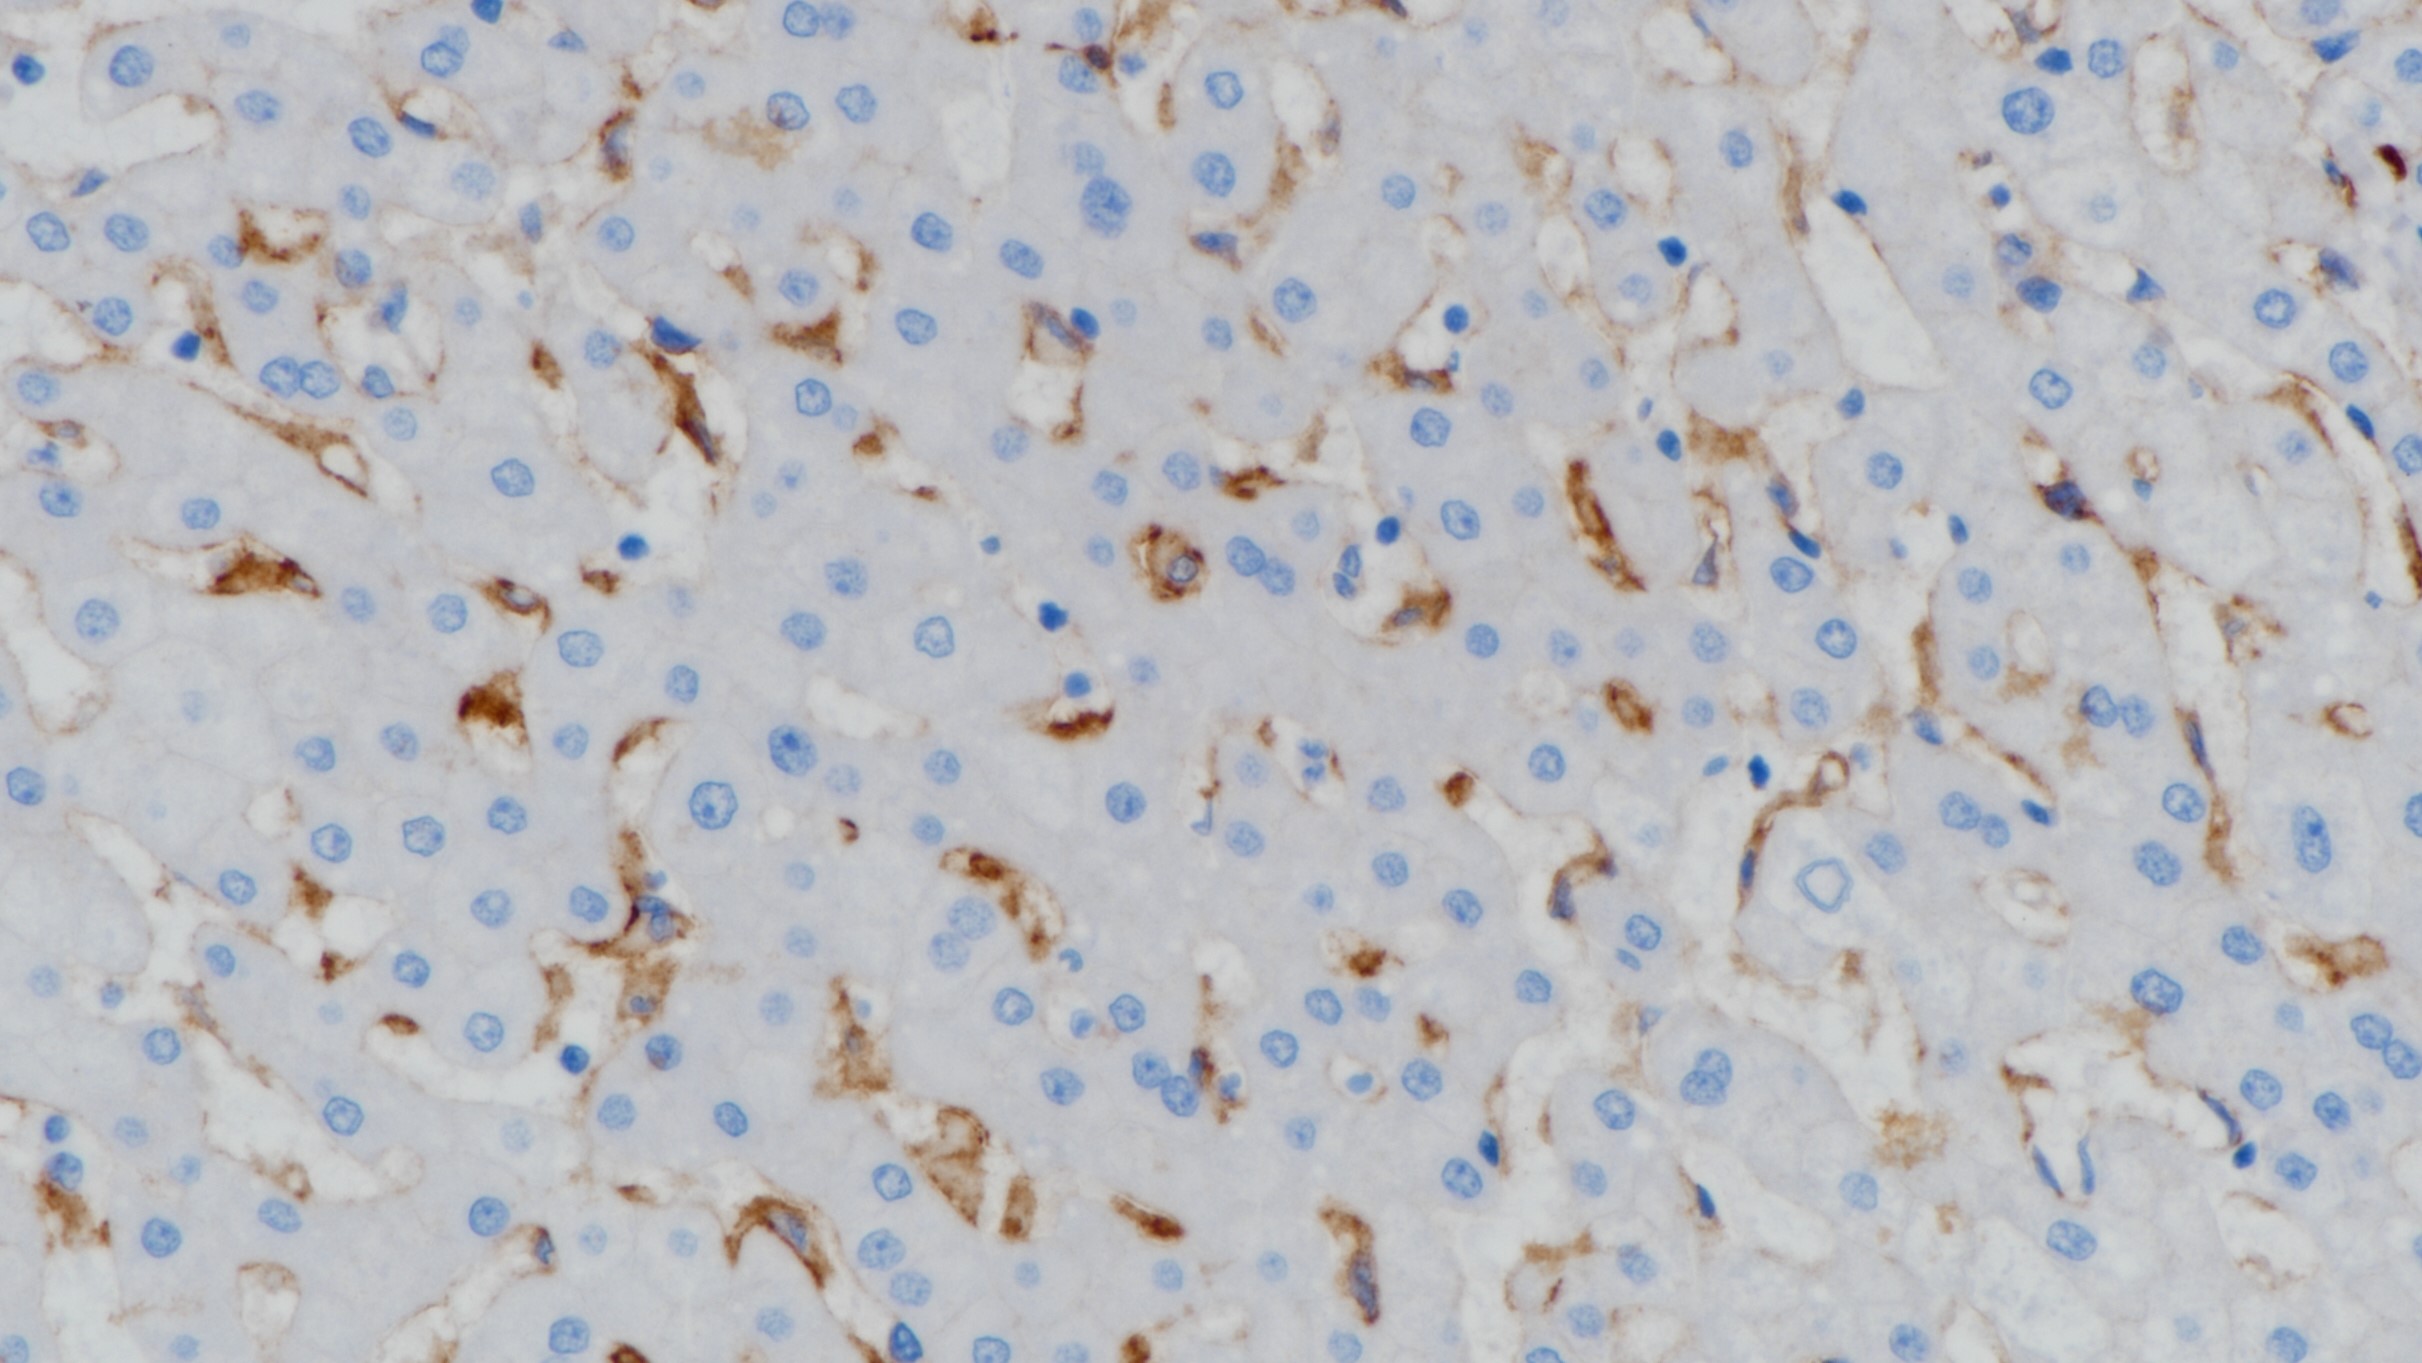
肝CD14(BP6111)染色

产品中心

扁桃体CD14(BP6111)染色
肝CD14(BP6111)染色
CD14 重组兔单克隆抗体
CD14即脂多糖(LPS)受体,在单核细胞和巨噬细胞中强表达,而在中性粒细胞上表达较弱。CD14通过糖基磷脂酰肌醇(GPI)锚定于细胞膜,其功能是作为LPS和LPS结合蛋白复合体的高亲和受体。可溶性CD14也可与LPS结合,在生理浓度下可作为LPS受体的诱导剂,而在高浓度下LPS 对细胞活化有拮抗作用。
Specifications
- 产品注册名称
- CD14抗体试剂(免疫组织化学)
- 目录号
- I1094
- 克隆号
- BP6111
- 亚细胞定位
- 细胞膜
- 阳性对照
- 阑尾
- 修复方式
- HIER
- 组织类型
- FFPE
- 规格
- 工作液:1.5mL/7mL
浓缩液:0.1mL/1mL
- 用途
- NMPA IVD
CE
Applicable platform
- Biolynx平台
- Leica平台
- Roche平台
- Dako平台
Reference
1.Gregory CD, et al. CD14 and apoptosis. Apoptosis. 1999; 4:11-20.
2.Wright SD, et al. CD14, a receptor for complexes of lipopolysaccharide (LPS) and LPS binding protein. Science. 1990; 249: 1431-33.


